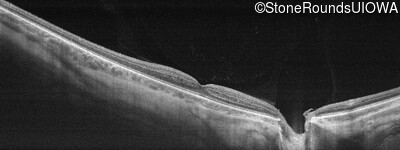
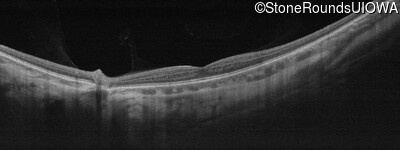
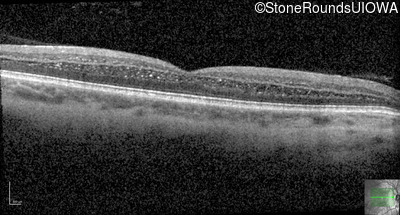
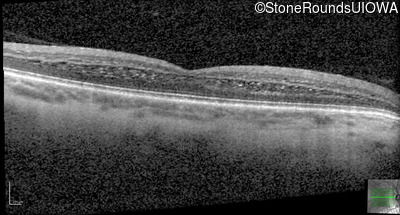
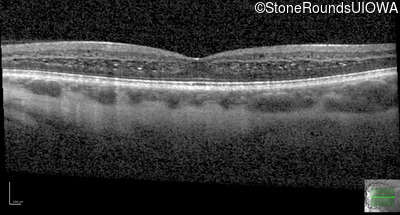

Case
SR2550
Student Mode
Wolfram Syndrome (IIIC2a)
Male
Male
Hidden
SR2550
Student Mode
Wolfram Syndrome (IIIC2a)
Male
Male
History
This 26 year old man had significant myopia since childhood and uncorrectable reduction of acuity since his mid teens. Optic nerve abnormalities were noticed on a routine exam at age 5 and a diagnosis of Retinitis Pigmentosa was suggested. His medical history is also positive for profound hearing loss at birth and type 1 diabetes mellitus.
Diagnosis & molecular findings
| Disease | Gene | Allele 1 variant(s) | Allele 2 variant(s) | Inheritance mode |
|---|---|---|---|---|
| Wolfram Syndrome | WFS1 | Ala684Val GCG>GTG | AD |